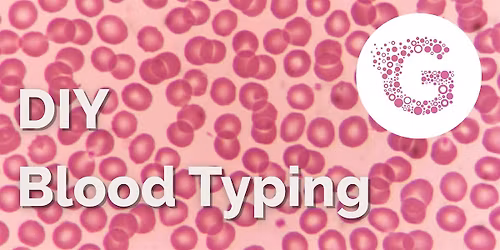
Whats Your Type? DIY Blood Typing in the Lab

Seeding Songs of Resistance
Schedule
Sat Jan 17 2026 at 01:30 pm to 02:30 pm
UTC-05:00Location
Prospect Park - Grand Army Plaza Entrance | Brooklyn, NY
About this Event
*** Meet at 1:15 at meet in the lobby of the Brooklyn Central Library!
In times of great change, in moments of collective grief or courage, music can be a lifeline — a way to connect, to center, to uplift, to resist, and to sing ourselves towards justice.
Join us in Prospect Park for what we are calling Seeding Songs of Resistance: a free community gathering where we’ll sing, teach, share, and invite songs that can serve us in moments of action — marches, demonstrations, protests, and beyond. This is a space to practice leading, learning, and singing songs that can rise up when we need them most — songs that carry joy, solidarity, defiance, and power.
Whether you’ve led songs at protests before or are just beginning to find your voice in this kind of space, all are welcome. We'll hold space for experimentation, collaboration, and rootedness in the values Gaia holds dear.
Some of the principles guiding the song-spinning in this space (an ever-changing and incomplete list):
🌱Equity and Justice ~ how might we use our songs to raise our voices for equity, justice, diversity, and the protection of community that have been/are being marginalized, oppressed, disenfranchised, and persecuted?
🌱 Nature as teacher ~ what do the miraculous systems of the natural world have to teach us about cooperation, resilience, healing, and balance?
🌱 Compassion ~ how do we hold compassion for people we disagree with, while demanding for the transformation of unjust systems?
🌱Accountability as love ~ What if the direct, honest, potentially disruptive thing is the kind thing? What if disrupting the status quo can be an act of love?
🌱Contrary/complex truths ~ For example, discomfort + safety can live in the same room. There is light and shadow within each of us. What do these contrary truths have to teach us?
🌱Our words matter ~ And so we choose them with care and intention. Any time we sing a word, we etch it into our hearts. Hate cuts both ways. Love heals both ways. How might we craft non-violent lyrics that ring powerfully enough to move mountains?
Together, we’ll explore how the musical practices we nurture here at Gaia — presence, improvisation, empowerment, expression, and deep listening — might ripple outward in service of justice, liberation, and collective care.
Bring water, winter layers, comfortable shoes, and any simple songs of resistance you'd like to teach, learn, or learn to lead. Let’s sing for the world we’re building.
LED and FACILITATED BY:
Sofía Campoamor (she/her) first started writing songs to make school projects more fun. This lighthearted approach to academics led her to study music at Yale University, where she performed a cappella music around the world as the first woman member of the Whiffenpoofs. School gave way to a music career; in 2022, Sofía’s word game project #wordlesong gained popularity on Tiktok and generated several of the songs for her debut album "if you knew, i couldn't tell,” an indie folk collection that blends her love of intricate vocal harmony with dreamy acoustic soundscapes to tell tales of love, longing and friendship. When she’s not touring or recording, Sofía volunteers for the nonprofit Hear Your Song, leading collaborative songwriting sessions with children managing serious illness and complex health needs. She also enjoys teaching music to kids ages 5 to 80 and singing with the Oratory Choir of St. Boniface. Sofía is so grateful to call Gaia Music Collective her creative home, and loves co-creating with the community at every collaborative open mic, songwriting circle, and choir!
🌱 🌿 🌳
LOW-PRESSURE PARTICIPATION
Gaia Music Collective events are participatory, but low-pressure. You'll be invited to sing along and make music with us, but we encourage you to draw your own boundaries and engage at your own pace - we pride ourselves in creating a judgment-free community where you can express yourself however feels right!
LATE ARRIVALS
We ask that you arrive no later than 30 minutes after start time, after which we close the doors (lovingly) in order to preserve the intimacy and trust of the musical container we’re building. Thank you for understanding!
CANCELLATION POLICY
Tickets are refundable up to 24 hours before the event, after which we are no longer able to offer refunds. This policy helps us keep these events financially sustainable for both our community and our team. If you RSVP but are no longer able to come, please let us know so that we may offer your spot to someone else! We want as many people to be able to experience these gatherings as possible, and since capacity is limited, each spot is precious.
For more info, contact us at [email protected].
MEDIA CONSENT
Because we want to share what we’re up to with people who can’t join us in person, there may be photographers and videographers present — by attending, you consent to being a part of that media, some of which may be posted online! If you have any questions or concerns, please email us at [email protected].
NO ONE TURNED AWAY FOR LACK OF FUNDS
Gaia is funded by sliding scale ticket donations, with a “no one turned away for lack of funds” policy. It is of the utmost importance to us that these events remain affordable and accessible - we never want money to be a barrier to making music together. If a ticket scale is financially prohibitive to you, feel free to donate outside of the scale at whatever amount is sustainable for you, or to email us at [email protected] for volunteer opportunities or assistance!
COMMUNITY GUIDELINES
At Gaia Music Collective, we are dedicated to building a community where creativity, collaboration, and care thrive. The values listed here shape how we work together, how we engage with the world, and how we move toward upholding these principles.
OUR MISSION
Gaia Music Collective is an NYC-based creative community seeking to foster a more connected world through collective music-making. Founded in June of 2021 in a living room in Brooklyn, this project was born out of a desire to create accessible, inclusive, playful spaces for people to explore connection, expression, healing, and release through collaborative song - spaces where folks feel empowered to make music free of judgment or expectation, and to make new friends as our full, beautiful, authentic selves.
We believe that communal music-making is a fundamental human practice, and this project seeks to build spaces for folks to nurture their relationship to music, whether they're shower singers, professional musicians, or anything in between.
All are welcome in this community. Gaia seeks to foster spaces of belonging for humans of all ages, races, genders, sexual orientations, classes, religions, abilities, national origins, languages, and musical experiences. All we ask is that you bring an open mind, a desire to connect, and a willingness to leave judgment of self and others at the door.
FAQ
Have any questions that haven't been answered here? Check out our Event FAQs!
🏡
Where is it happening?
Prospect Park - Grand Army Plaza Entrance, Flatbush Ave, Brooklyn, United StatesEvent Location & Nearby Stays:
USD 0.00